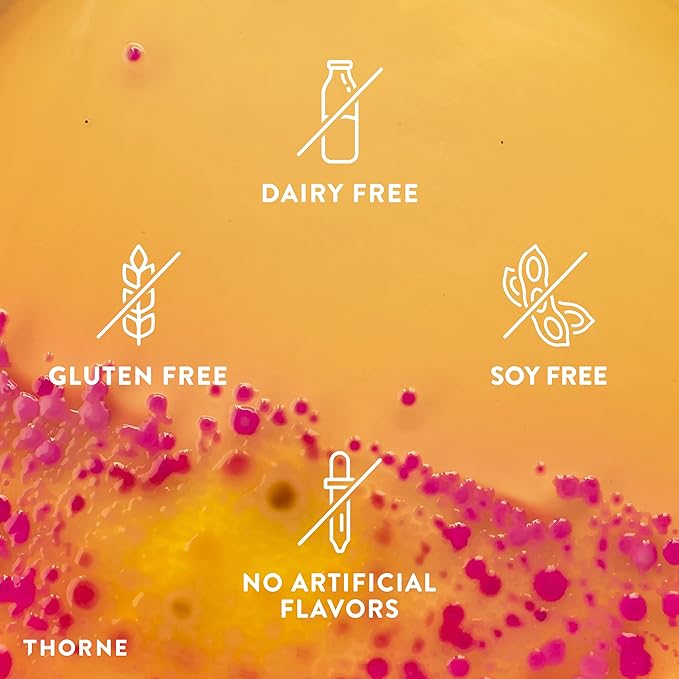
Metabolic Health | Thorne® | 120 Capsules

Metabolic Health | Thorne® | 120 Capsules
Description
Nutritional Support for General Wellness
Metabolic Health by Thorne® is a dietary supplement featuring botanical extracts such as bergamot and curcumin. Designed to complement a healthy lifestyle, it supports general metabolic processes and overall well-being.
Features
• Contains bergamot and curcumin phytosomes for enhanced bioavailability.
• Promotes overall wellness with antioxidant properties.
• Manufactured to meet Thorne’s rigorous quality standards.
• Free from gluten, dairy, and other common allergens.
Ingredients
Medicinal Ingredients (Per 2 Capsules):
• Bergamot Phytosome: 500 mg
• Curcumin Phytosome (Meriva): 250 mg
Non-Medicinal Ingredients:
Calcium Laurate, Hypromellose Capsule, Silicon Dioxide
Recommended Use
Take 2 capsules twice daily or as directed by your healthcare practitioner.
Cautions
• Consult a healthcare professional prior to use, especially if you are pregnant, nursing, taking medication, or have a medical condition.
• This product is not intended for use by individuals allergic to any of its ingredients.
• Keep out of reach of children. In case of accidental overdose, seek medical assistance immediately.
About the Brand
Thorne® is committed to providing high-quality, science-backed supplements that promote overall wellness. Every product is crafted with care to meet rigorous purity and safety standards.
Legal Disclaimer
This product is a dietary supplement and is not intended to diagnose, treat, cure, or prevent any disease. Always read product labels and follow usage instructions. Actual product packaging and materials may vary from the information provided.

Choose options

Keep me updated
Newsletter
Subscribe today and get $10 off when you spend over $100, plus receiving other exclusive offers.
Free Delivery
Local Delivery (BC Wide): $65+ | Canada: $120+ | US: $155+
Satisfied or refunded
30 Day Return Policy
Top-notch support
Secure payments